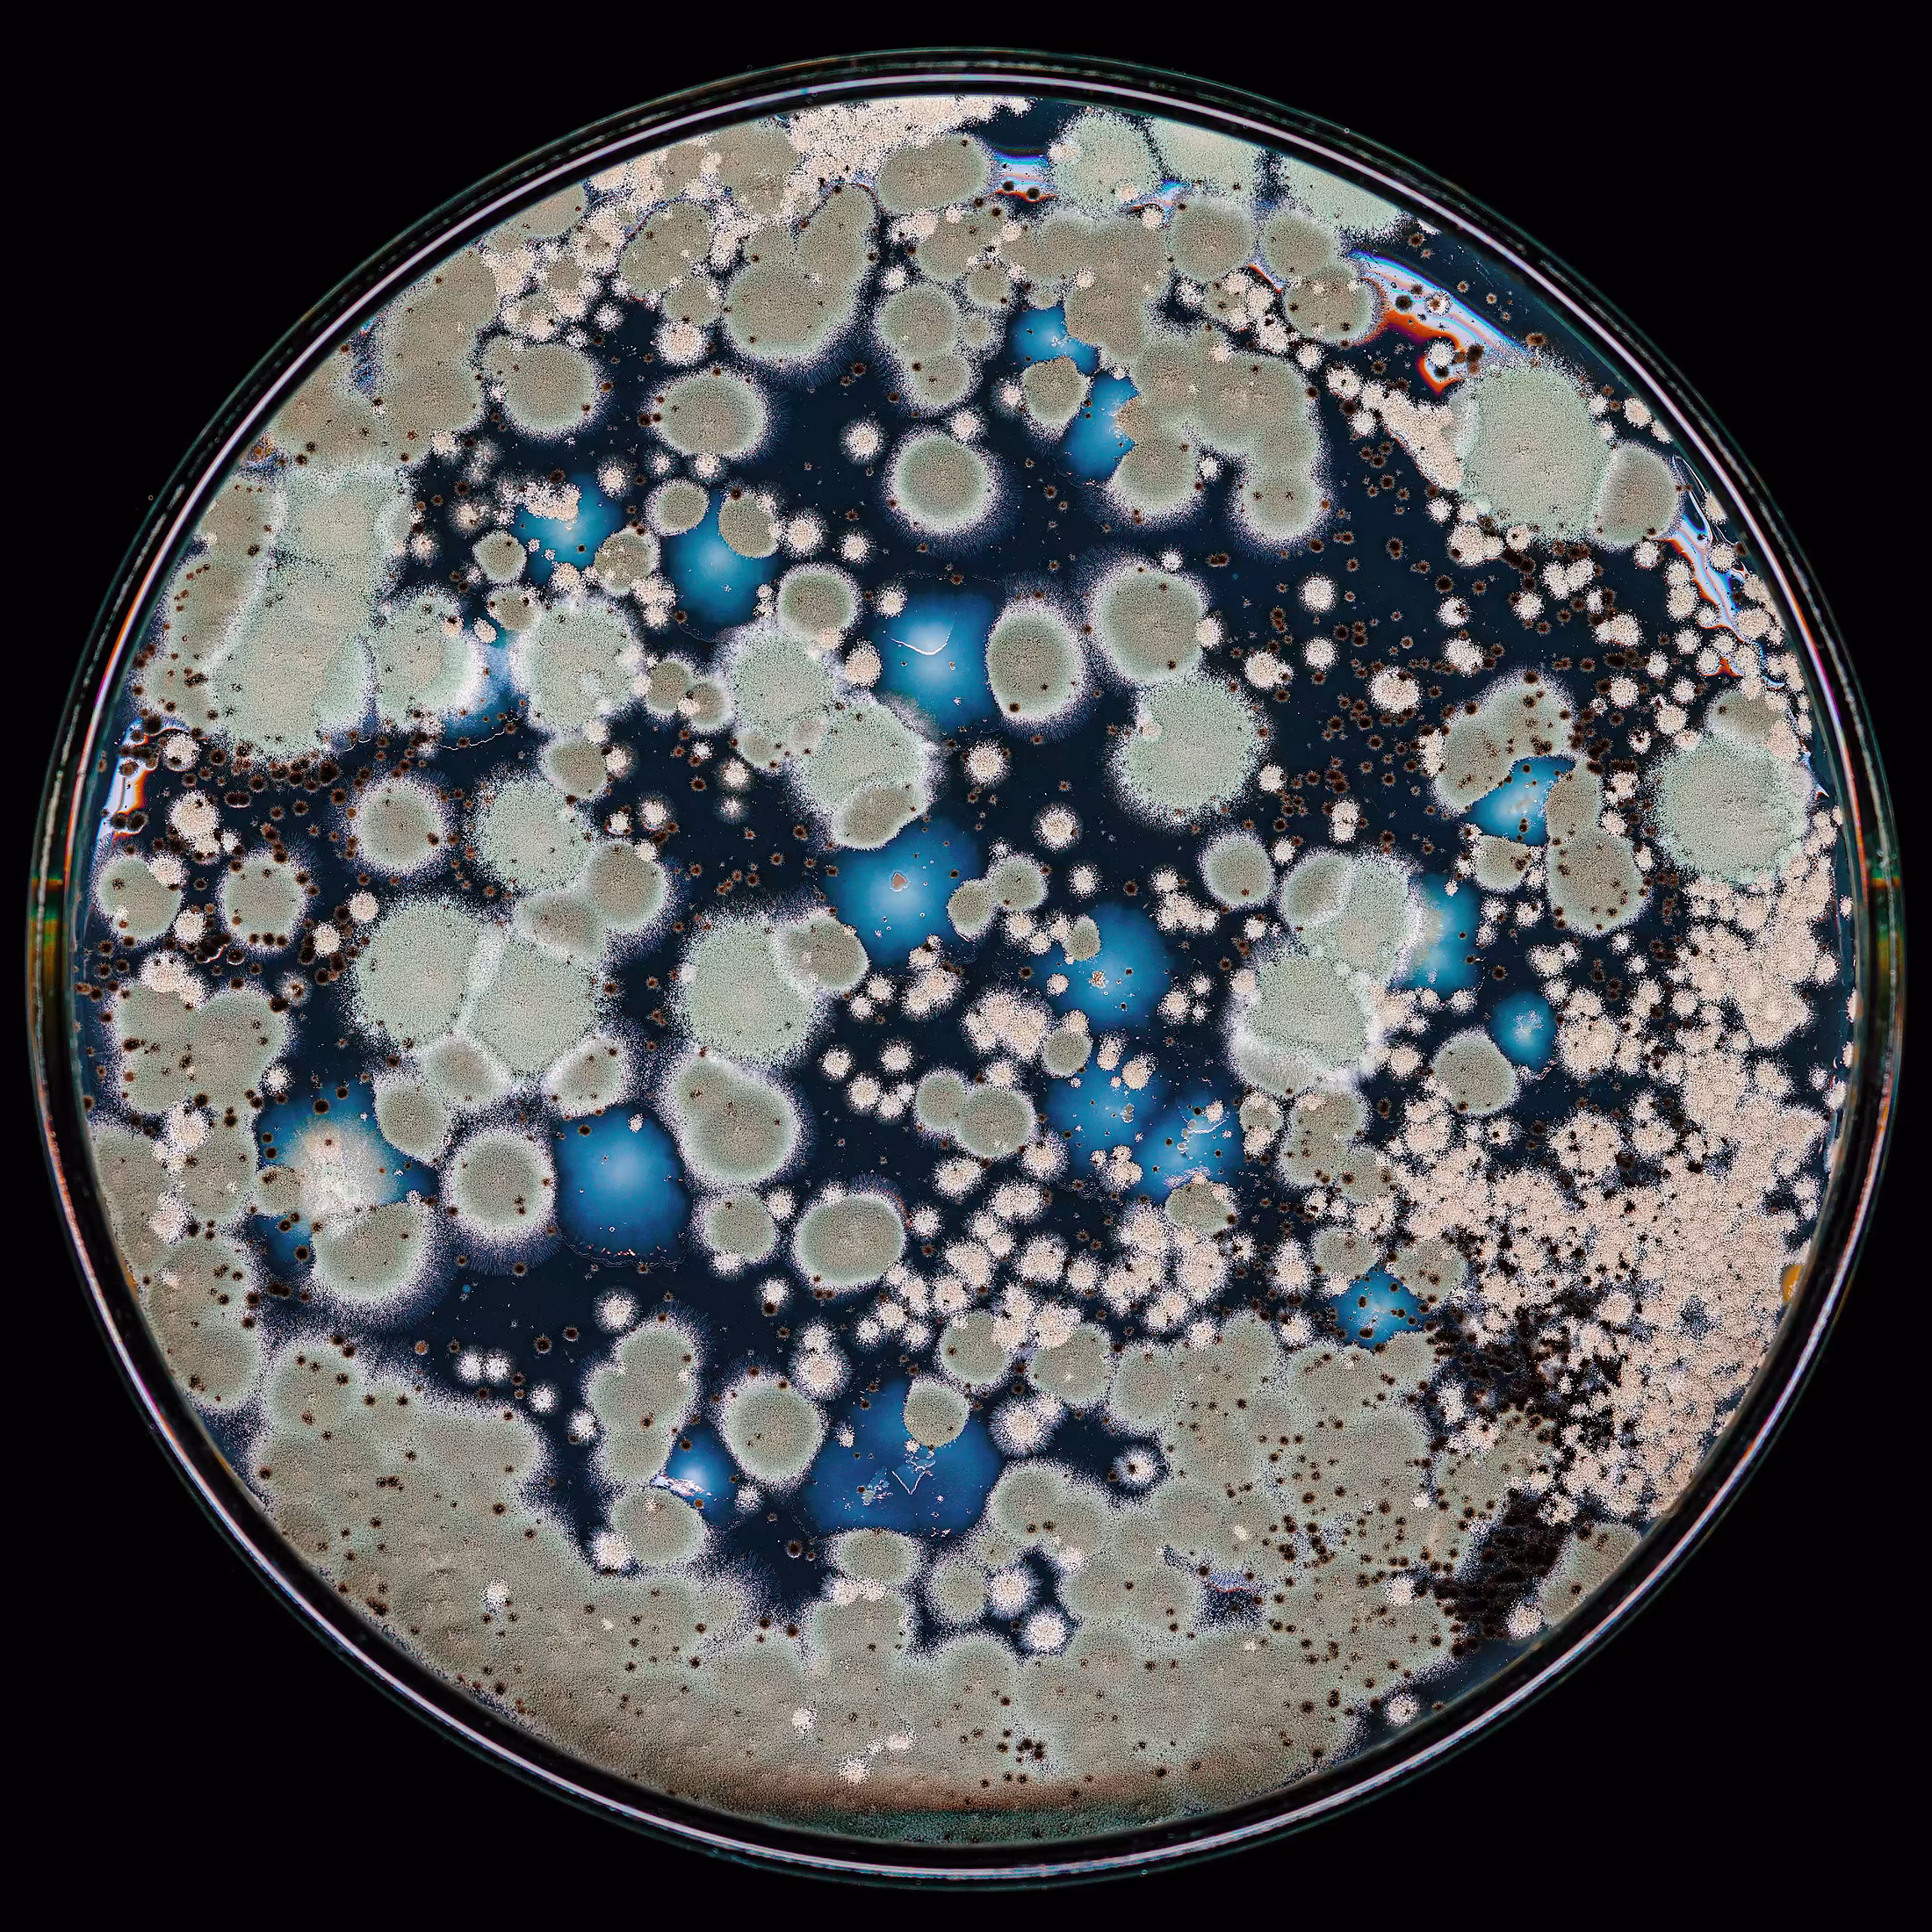

Several years ago, the artists DAT.XYZ began the unauthorised collection of microbiological samples by illicitly swabbing* the surface of world-famous artworks ... and then legging it.
Back in their laboratory they grow new artworks directly from these swabs - a living collection of pirated masterpieces.
'This is a real, new kind of generative art born directly from nature herself. By stealing microbiological data from the surface of major artworks and bringing it to life - we resurrect dead painters and mutate living artists - a physical bridge is created between their original artworks and these NFTs.'
The growth of each artwork is captured on industrial, high-resolution cameras and processed into a collection of evolving video loops. These beautiful Attenborough-esque, detailed time-lapse films, bearing their original artists' name, become the NFTs (New Fungus Tokens! ;)
*Please note - no works of art were harmed in this process.
DAT.xyz